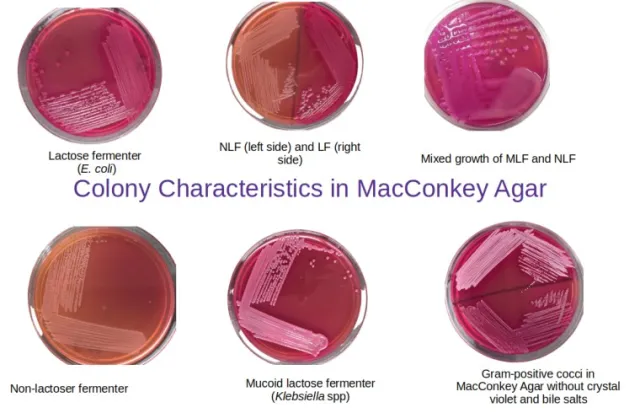
Colony characteristics in MacConkey Agar
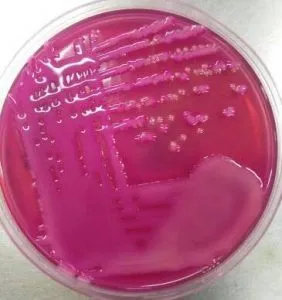
Mixed growth of mucoid Lactose fermenting colonies and NLF colonies in MacConkey Agar - Mixed growth of mucoid lactose fermenting colonies and NLF colonies in MacConkey agar
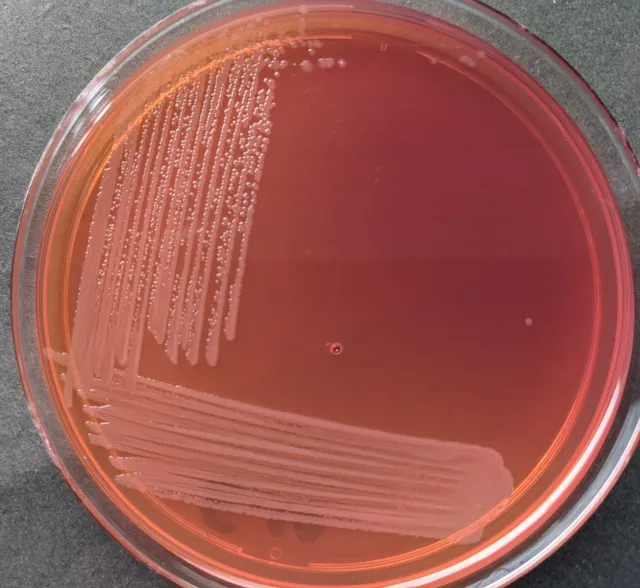
Pale, non-lactose fermenting colonies of Salmonella in MacConkey Agar - Pale, non-lactose fermenting colonies ofSalmonellain MacConkey Agar
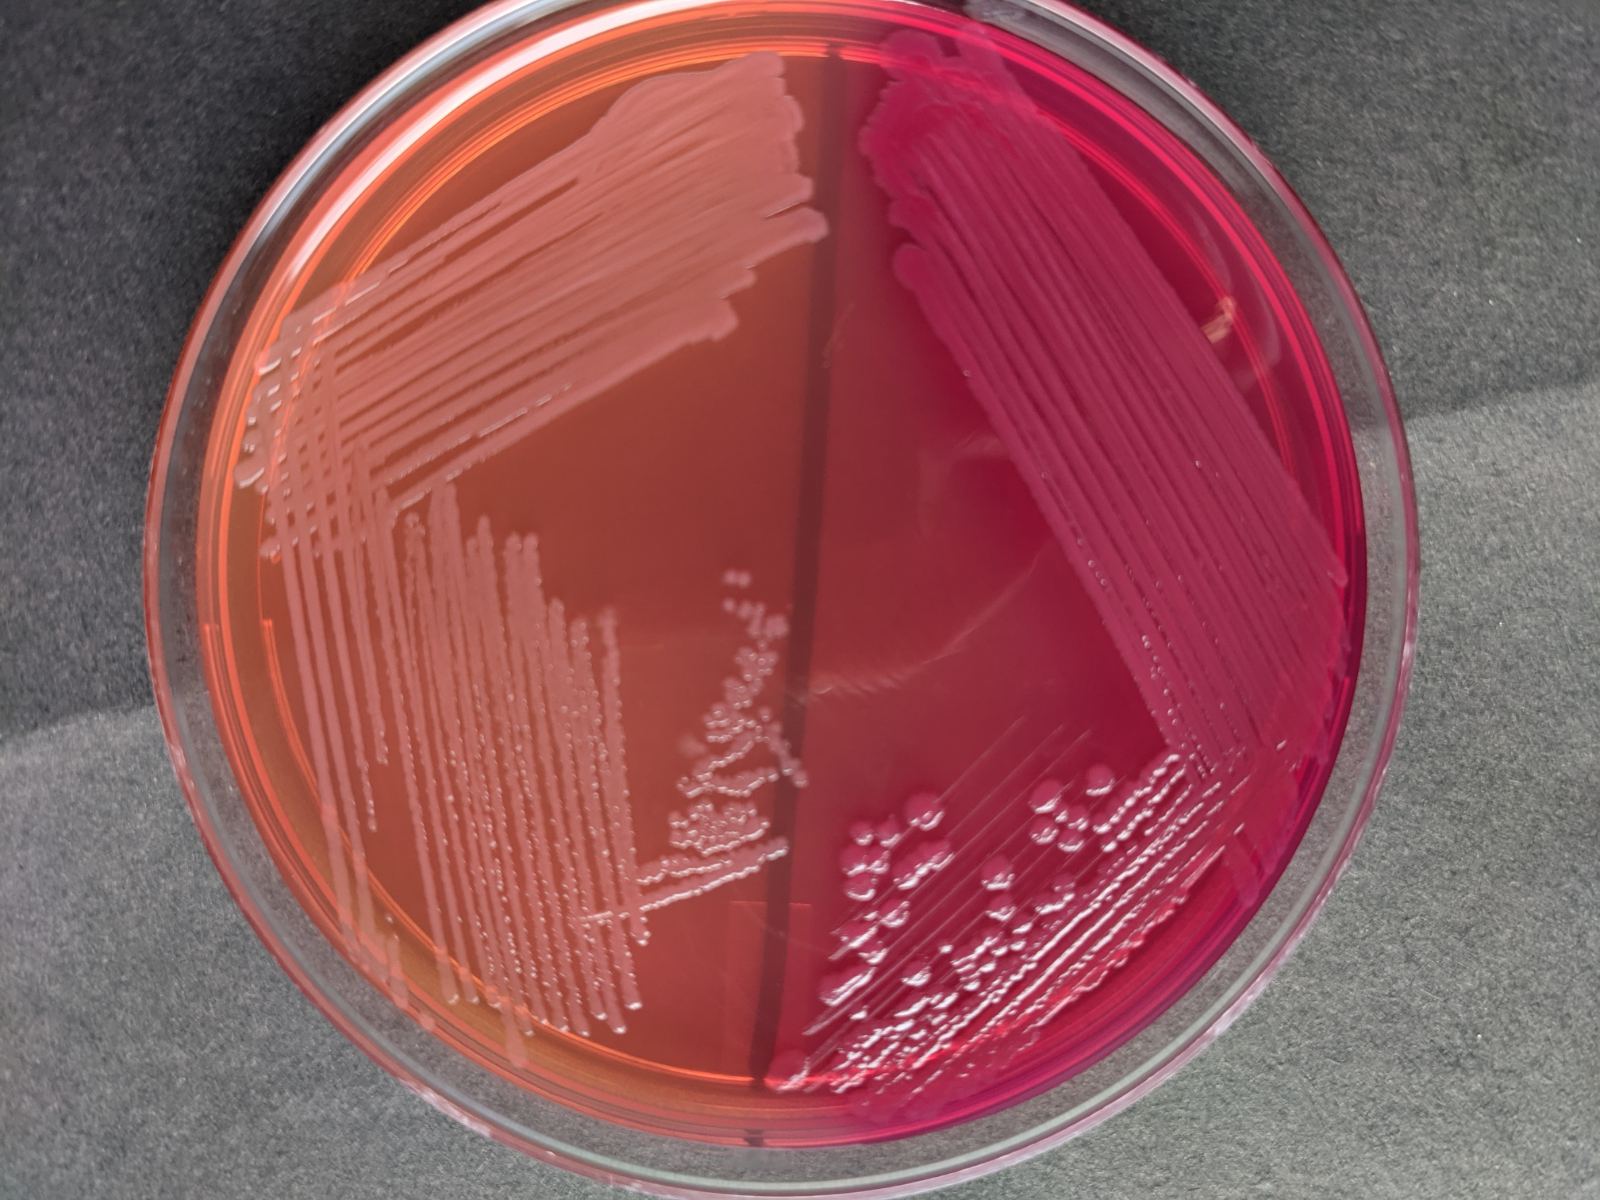
Pale (NLF) and pink (LF) colonies on MacConkey Agar - Pale (NLF) and pink (LF) colonies on MacConkey Agar
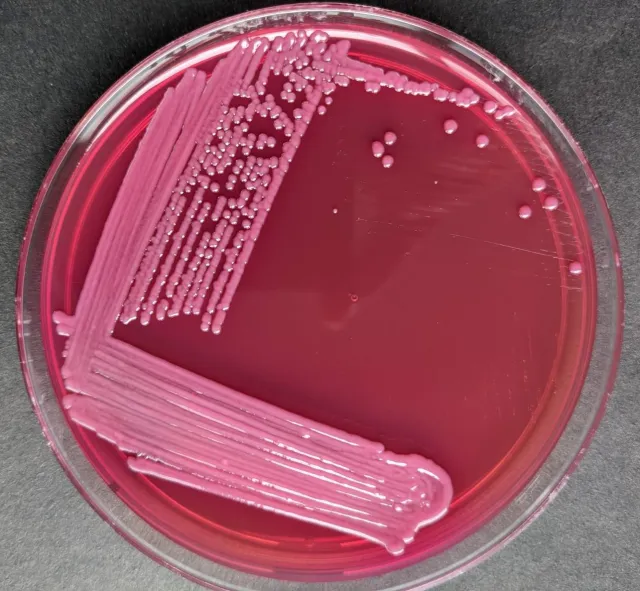
Pink-mucoid colonies of Klebseilla pneumoniae in MacConkey Agar - Pink-mucoid colonies ofKlebsiella pneumoniaein MacConkey Agar
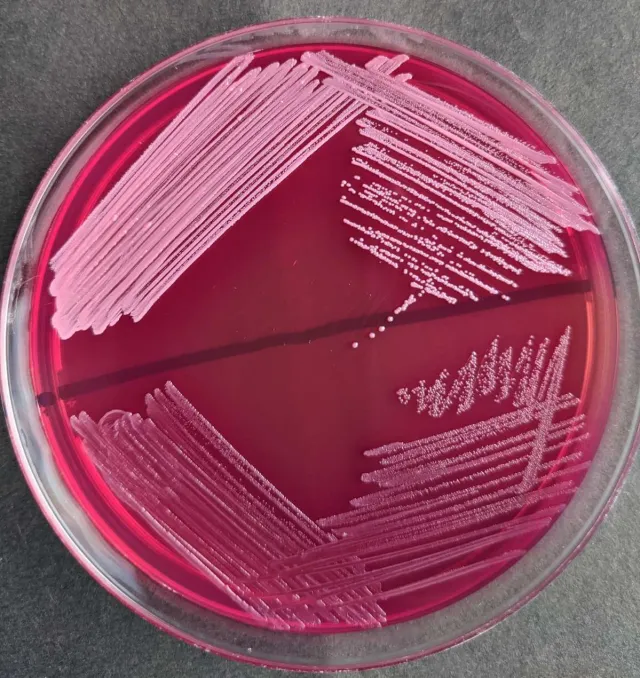
- Light pink, small colonies ofS. aureus(above) and dark pink-red, minute colonies ofEnterococcus(below) on MacConkey agar without bile salts and crystal violet.

MacConkey agar (MAC) is a selective and differential bacterial culture media. MacConkey medium is selective for gram-negative bacteria and differentiates the gram-negative bacteria based on lactose metabolism.
The media was first developed by Alfred Theodore MacConkey in 20th century.
Composition of MacConkey Agar
Key components of the MacConkey medium include crystal violet dye, bile salts, lactose, and neutral red (pH indicator).
| Ingredient | MacConkey Agar (g/L) |
|---|---|
| Peptone | 17 g |
| Polypeptone | 3 g |
| Lactose | 10 g |
| Bile salts | 1.5 g |
| Sodium chloride | 5 g |
| Agar | 13.5 g |
| Neutral red | 0.03 g |
| Crystal violet | 0.001 g |
| Distilled water | 1 L |
| Final pH | 7.1 |
Crystal violet dye and bile salts prevent the growth of Gram-positive bacteria and fastidious Gram-negative bacteria (such as Neisseria and *Pasteurella)*making it favorable for the growth of gram-negative bacteria. Since Gram-negative enteric bacteria possess a bile-resistant outer membrane, they remain unaffected by bile salts.
Lactose present in the medium is fermented by bacteria to form lactic acid that decreases the pH of the agar, and turns the indicator (neutral red) pink, thus differentiating lactose fermenters from non-lactose fermenters.
Other ingredients such as enzymatic digest of gelatin, casein, and animal tissue provide nitrogen, vitamins, minerals, and amino acids essential for growth. Sodium chloride provides osmotic balance and supplies essential electrolytes for transport. Agar is incorporated as the solidifying agent
Principle of MacConkey Agar
MacConkey agar contains four key ingredients (lactose, bile salts, crystal violet, and neutral red) that make it a selective and differential media. Bile salts and crystal violet act as selective agentsthat inhibit the growth of Gram-positive organisms, and aid in the selective growth of non-fastidious gram-negative bacteria. Lactose acts as a source of carbohydrates. Lactose-fermentingbacteria produce pink-redcolonies, after fermenting the lactose to acids and dropping the pH of the indicator (neutral red) present in the medium. Since, non-fermenters can’t utilize lactose, colonies appear colorless or transparent.
Encapsulated bacteria such as Klebsiella and Enterobacter produce capsules using lactose. This gives sticky, wet-appearing colonies on MacConkey medium.
Lactose Fermenters
Gram-negative enteric bacteria that grow on MacConkey medium are differentiated by their ability to ferment lactose. If the lactose is fermented the production of the acid drops the pH of the media. The drop in pH is indicated by the change of the neutral red indicator to pink (neutral read appears pink at pH below 6.8).

Strongly lactose fermenting bacteria produce sufficient acid which causes precipitation of the bile salts around the growth. It appears as a pink halo surrounding colonies or areas of confluent growth. A pink halo is not seen around the colonies of weaker lactose fermenting bacteria.
Lactose non-fermenters
Gram-negative bacteria that grow on MacConkey agar but do not ferment lactose appear colorless on the medium and the agar surrounding the bacteria remains relatively transparent.
Uses of MacConkey Agar Medium
- MacConkey agar is commonly used for the isolation of Gram-negative enteric bacteria.
- MacConkey is a commonly used media to differentiate members of Enterobacteriaceae. It differentiates between lactose-fermenting and nonfermenting gram-negative rods by the color of colonial growth.
- MacConkey agar is used for the selective isolation and identification of members of the family Enterobacteriaceae from feces, urine, wastewater, and foods.
Preparation of MacConkey Agar
- Weigh and suspend 50 grams of MacConkey agar powder in 1 Litre of purified water and mix thoroughly. Read and follow the instruction of the manufacturer if you have purchased dehydrated agar media from a commercial supplier.
- Heat with frequent agitation and boil for 1 minute to completely dissolve the powder.
- Autoclaveat 121°C for 15 minutes.
- Cool to 45-50°C, mix well, pour about 20- 25ml into sterile Petri plates and allow to solidify.
- After solidification of the plates, label the media plates with the name and date of preparationLabeling should always be done on the backside of the media plate as lids could be interchanged.
- Store inverted (with lids down) at 2-8°C until use.
You can also purchase the ready-made MacConkey medium from commercial suppliers.
Result and Interpretation
Pink-red colonies: Pink-red colonies on MAC medium indicate the presence of lactose fermenting bacteria. Examples include Escherichia coli, Klebsiellaspp, Citrobacter, Enterobacter, etc.
Colorless colonies/pale colonies (colonies similar to the color of the media): Colorless or pale colonies on MAC medium indicate that the test organism is a non-lactose fermenter. Examples include species of Salmonella, Shigella, Proteus, Providencia, Pseudomonas, Morganella, etc.
Colony Morphology on MacConkey Agar
Besides differentiating on the basis of color, colonies on MacConkey medium can further be presumptively identified based on their colonial appearances (shape, size, margin, time of growth, etc). Some of them are enlisted below:
| Organism | Type | Colony characteristics |
|---|---|---|
| Escherichia coli | Lactose fermenter | E. coli gives flat, dry, pink, non-mucoid colonies with a surrounding darker pink area of precipitated bile salts. |
| Klebsiella spp | Lactose fermenter | Colonies typically appear large, mucoid, and pink, with pink-red pigment usually diffusing into the surrounding agar |
| Citrobacter spp | Late lactose fermenter | Appear as non-lactose fermenter (NLF) up to 24 hours; however, after 48 hours colonies are light pink. |
| Enterobacter spp | Lactose fermenter | Pink, mucoid colonies but smaller than Klebsiella spp. |
| Serratia spp | Late lactose fermenter | S. marcescens may be red-pigmented, especially if the plate is left at 25°C |
| Proteus spp | Non-Lactose Fermenter | Pale colonies with swarming, characteristic foul smell. |
| Shigella spp | Non-Lactose Fermenter except S.sonnei which is a late lactose fermenter | Pale colonies,1-2 mm, flat colonies with jagged edges |
| Providencia spp | Non-Lactose Fermenter | Colonies are colorless, flat, 2-3 mm in diameter, and do not swarm. |
| Salmonella spp | Non-Lactose Fermenter | Colorless colonies, convex, 2-3 mm with a serrated margin. |
| Pseudomonas spp | Non-Lactose Fermenter | Colorless, flat, smooth colonies, 2-3 mm in diameter with greenish to brownish pigmentation. |
| Yersinia spp | Non-Lactose Fermenter | Colonies may be colorless to peach |
| Gram-positive bacteria | No growth |
In MacConkey agar without crystal violet and bile salts
**Note:**Gram-positive organisms are inhibited in MacConkey agar with bile salts and crystal violet, however, in a different formulation where bile salt and crystal violet are not incorporated, Gram-positive organisms also appear as lactose fermenters but are smaller in size than gram-negative ones.
Quality Control of MacConkey agar
- Sterility testing: Incubate uninoculated plates of MacConkey for 48 hours at 35-37°C and observe for any growth. After 48 hours, the sterility test plate should remain clear. Discard the whole lot if any colonies are seen.
- Performance testing: Inoculate known standard strains on MacConkey agar plates, incubate for 18-24 hours at 35-37°C, and observe for growth and colony characteristics.
| Organism | Used as | Colony morphology |
|---|---|---|
| Escherichia coli ATCC 25922 | Positive control for lactose fermentation | Lactose fermenting pink colonies |
| Pseudomonas aeruginosa ATCC 27853 | Positive control for non-lactose fermentation | Non-lactose fermenting colonies with or without pigmentation. |
| Streptococcus pneumoniae ATCC 49619 | Negative control | No growth |
Modifications of MacConkey Agar
- MacConkey Agar without Crystal VioletIt is a differential medium but is less selective than MacConkey agar. The lack of crystal violet permits the growth of Staphylococcus and*Enterococcus.*Staphylococci produce pale pink to red colonies and enterococci produce compact tiny red colonies either on or beneath the surface of the medium. The medium is also used to separate Mycobacterium fortuitum and M. chelonae from other rapidly growing mycobacteria.
- MacConkey Agar, CS (“Controlled Swarming”):  MacConkey agar without crystal violet or salt is used to prevent the swarming of Proteusspp.
- Sorbitol MacConkey Agar:Sorbitol MacConkey agar is a variant of MacConkey agar, it containssorbitol instead of lactose as fermentable sugar. The contents of Sorbitol MacConkey agar are sorbitol, peptone, bile salts, sodium chloride, neutral red, crystal violet, and agar. E.coli(VTEC) 0157 is non-sorbitol fermenting, producing colorless colonies. Most other E.coli strains and other enterobacteria ferment sorbitol. Sorbitol-fermenting organisms produce pink colonies
Quality control of Sorbitol MacConkey agar
Escherichia coli ATCC® 25922: Good growth, pink colonies are sorbitol positive Escherichia coli ATCC® 35150: Good growth, colorless colonies are sorbitol negative
References and further readings
- Allen, M. E. (2005, September 30). MacConkey Agar Plates Protocols. https://www.asmscience.org/content/education/protocol/protocol.2855
- Jung, B., & Hoilat, G. J. (2021). MacConkey Medium. In StatPearls. StatPearls Publishing. http://www.ncbi.nlm.nih.gov/books/NBK557394/